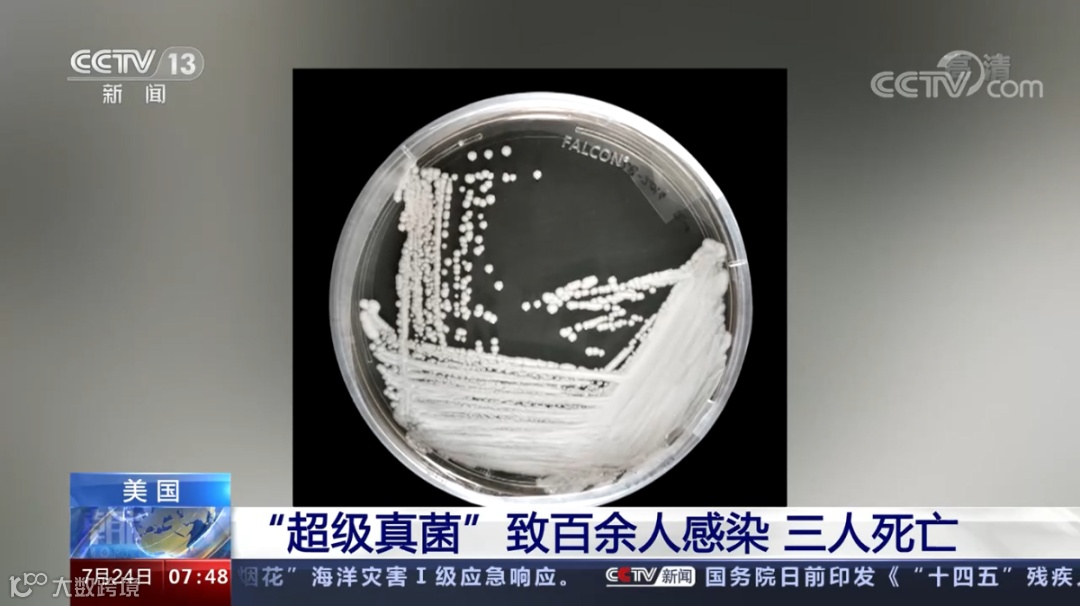
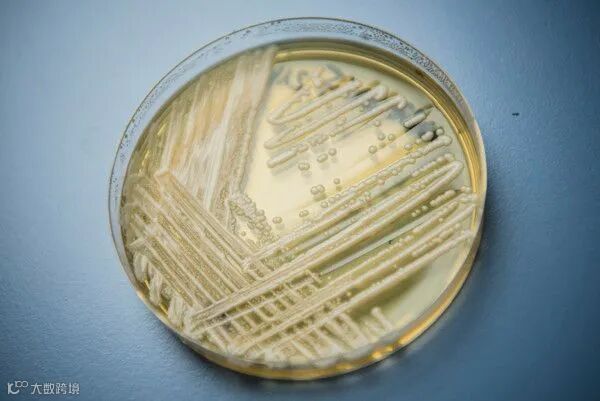
耳念珠菌.jpg
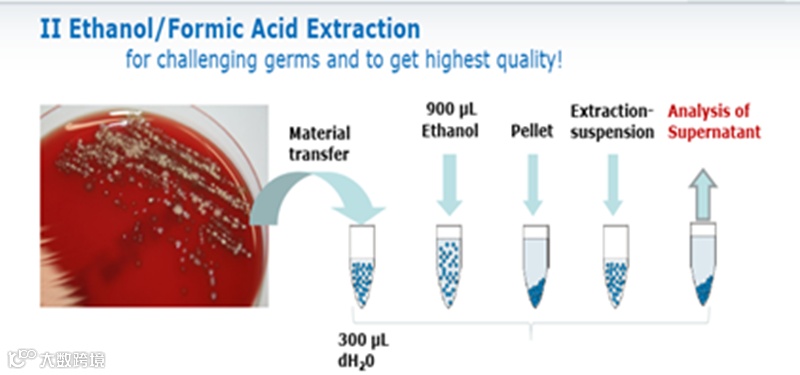
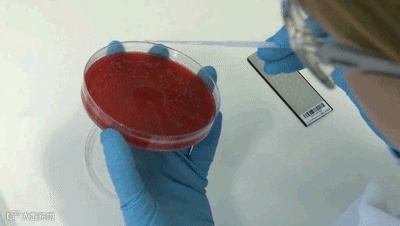

近日,据海外网、中国新闻网等多家媒体报道,美国出现“超级真菌”传播事件致3人死亡,而且研究发现此“超级真菌”对现有的多种抗真菌药物都具有耐药性。
因其强韧的耐药性,现“超级真菌”感染的致死率已经达到60%,在美国被列为“紧急威胁”!!!
通过追溯发现“超级真菌”曾经引起多起流行事件:
美国卫生当局报告说,美国出现了一种叫耳念珠菌(耳道假丝酵母菌(C. auris))的新型“超级病菌”,已造成至少13人感染,其中4人死亡
耳念珠菌又在美国多地爆发,感染600多例
中国报道感染18例,没有爆发疫情
那么问题来了——
除了现已成为“超级真菌”一员的耳念珠菌,未来还有哪些假丝酵母菌可能存在威胁呢?
其实早在2016年VITEK MS微生物质谱鉴定系统已给大家做出“回答“,并做了风险提醒。
 如上图聚类分析,除了耳念珠菌还有其他假丝酵母菌也能被VITEK MS微生物质谱鉴定系统单独鉴定出来。
如上图聚类分析,除了耳念珠菌还有其他假丝酵母菌也能被VITEK MS微生物质谱鉴定系统单独鉴定出来。

包括:拟平滑念珠菌(Candida orthopsilosis)、似平滑念珠菌(Candida metapsilosis)、近平滑念珠菌(Candida parapsilosis)等致病性假丝酵母菌,已被美国CDC列为的可引起高度感染风险的真菌种类,一旦将这些隐藏的“杀手”暴露在众目睽睽之下,医护人员也能够从容面对。

耳念珠菌属于真菌类细菌,目前具有以下特征:
耐药性耳念珠菌有不同的地域遗传特性
通过血液感染致死率高且容易在患者间传播,真菌扩散到血液、大脑或心脏,甚至会夺人性命
耳念珠菌鉴别困难,用一般传统的方法、显微镜观察进行鉴别,它和普通的念珠菌几乎没有分别,因此误诊可能性较大
由于酵母菌本身有结实的细胞壁,需充分地把孢子破壁,有效蛋白提取成为质谱鉴定的关键和准确识别的前提
目前微生物质谱鉴定已成为公共卫生监测和临床快速识别病原菌的主流方法,其中提取方法包括传统和快速方法
30min
耗 时

挑单菌落酵母
加入300ul无菌水
加入900ul乙醇,涡旋混匀,离心
加入甲酸乙腈,静置后,涡旋混匀
加样1ul样品
加基质液
风干
上机分析
1min
耗 时





1挑单菌落酵母
2.涂在测试靶板加入酵母预处理溶液

3.加基质

4.上机分析


质谱方法在公共卫生防控中识别病原菌已非常成熟,在未来的公共卫生防控手段中将越来越重要,如果需要了解更多关于质谱方法的应用和相关内容,欢迎联系我们!



